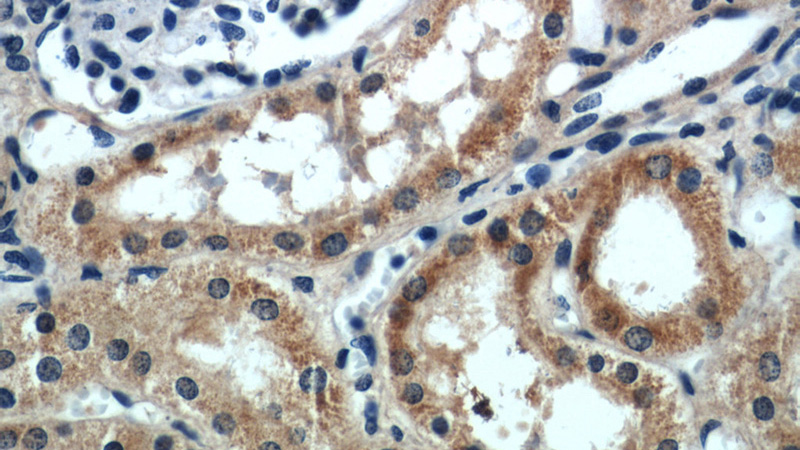
Immunohistochemical of paraffin-embedded human kidney using Catalog No:115357(SLIT2-Specific antibody) at dilution of 1:50 (under 40x lens)

-
Product Name
SLIT2-Specific antibody
- Documents
-
Description
SLIT2-Specific Rabbit Polyclonal antibody. Positive FC detected in HEK-293 cells. Positive IHC detected in human kidney tissue, human breast cancer tissue. Positive WB detected in HEK-293 cells, mouse brain tissue. Observed molecular weight by Western-blot: 130-140 kDa,200 kDa
-
Tested applications
ELISA, IHC, WB, FC
-
Species reactivity
Human,Mouse,Rat; other species not tested.
-
Alternative names
FLJ14420 antibody; SLIL3 antibody; Slit 2 antibody; slit homolog 2 (Drosophila) antibody; Slit homolog 2 protein antibody; SLIT2 antibody
-
Isotype
Rabbit IgG
-
Preparation
This antibody was obtained by immunization of Peptide (Accession Number: NM_004787). Purification method: Antigen affinity purified.
-
Clonality
Polyclonal
-
Formulation
PBS with 0.1% sodium azide and 50% glycerol pH 7.3.
-
Storage instructions
Store at -20℃. DO NOT ALIQUOT
-
Applications
Recommended Dilution:
WB: 1:200-1:2000
IHC: 1:20-1:200
-
Validations

HEK-293 cells were subjected to SDS PAGE followed by western blot with Catalog No:115357(SLIT2-Specific antibody) at dilution of 1:600

Immunohistochemical of paraffin-embedded human kidney using Catalog No:115357(SLIT2-Specific antibody) at dilution of 1:50 (under 10x lens)
Immunohistochemical of paraffin-embedded human kidney using Catalog No:115357(SLIT2-Specific antibody) at dilution of 1:50 (under 40x lens)

1X10^6 HEK-293 cells were stained with 0.2ug SLIT2-Specific antibody (Catalog No:115357, red) and control antibody (blue). Fixed with 4% PFA blocked with 3% BSA (30 min). Alexa Fluor 488-congugated AffiniPure Goat Anti-Rabbit IgG(H+L) with dilution 1:1500.
-
Background
SLIT2, also named as SLIL3, is thought to act as molecular guidance cue in cellular migration, and function appears to be mediated by interaction with roundabout homolog receptors. During neural development it is involved in axonal navigation at the ventral midline of the neural tube and projection of axons to different regions. SLIT1 and SLIT2 seem to be essential for midline guidance in the forebrain by acting as repulsive signal preventing inappropriate midline crossing by axons projecting from the olfactory bulb. In spinal chord development, SLIT2 may play a role in guiding commissural axons once they reached the floor plate by modulating the response to netrin. SLIT2 may be implicated in spinal chord midline post-crossing axon repulsion. In vitro, only commissural axons that crossed the midline responded to SLIT2. In the developing visual system it appears to function as repellent for retinal ganglion axons by providing a repulsion that directs these axons along their appropriate paths prior to, and after passage through, the optic chiasm. In vitro, it collapses and repels retinal ganglion cell growth cones. SLIT2 seems to play a role in branching and arborization of CNS sensory axons, and in neuronal cell migration. It seems to be involved in regulating leukocyte migration. The antibody is specific to SLIT2.
-
References
- Gibson DA, Tymanskyj S, Yuan RC. Dendrite self-avoidance requires cell-autonomous slit/robo signaling in cerebellar purkinje cells. Neuron. 81(5):1040-56. 2014.
Related Products / Services
Please note: All products are "FOR RESEARCH USE ONLY AND ARE NOT INTENDED FOR DIAGNOSTIC OR THERAPEUTIC USE"
